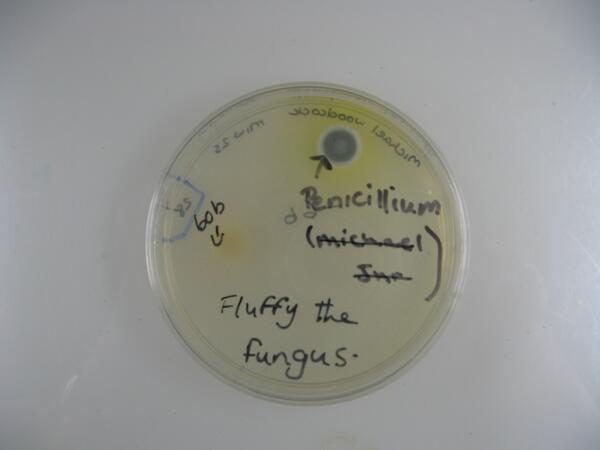
David Comont tweet media

David Comont
50 posts


David Comont
@DavidComont
Ecologist and plant biologist, Postdoctoral scientist working at Rothamsted Research.
Katılım Ocak 2013
30 Takip Edilen123 Takipçiler
David Comont retweetledi

Fancy a chat about #blackgrass Come to the @Rothamsted stand to speak to us. @RHull76 @ClaudiaLowe1 and @HMetcalfe1 all here #Cereals2017

English

Just finished my Rothamsted #RResDays16 presentation. Hope everyone enjoyed my many photos of blackgrass...

English

Thanks to everyone who visited the @BlackGrassRI at #cerealsevent today. Blackgrass breakfast 8:30 tomorrow on the @Rothamsted @BBSRC stand.
English
David Comont retweetledi

Problem black-grass in your wheat? Want to take part in a new resistance study? Come see us on the HGCA/ Rothamsted stands #cereals14
English

@AberMycol And here's your Sarcoscypha close up. Congrats to the unknown #BR12110 student who made these slides

English

@AberMycol And another gametangia here.... well done to all the #BR12110 students that managed to identify these.

English

@AberMycol #BR12110 When two fungal mating types collide. Formation of gametangia in phycomyces blakesleeanus

English

Last in the series of #BR12110 practicals today. Oomycetes, Basidiomycetes, Ascomycetes, and Zygomycetes galore!
Română

Is it a Bird? is it a plane? no.. it's the cytoplasmic streaming of a slime mould from last weeks prac class vimeo.com/87408390 #BR12110
English
David Comont retweetledi

#BR12110 C.diff treatment with faeces. Legally, is poo a tissue or a drug? wired.com/wiredscience/2…
English

@AberMycol Putting the fun into fungal contamination… Some more microbial diversity from today’s #BR12110 labs!
English

Just back from a great fieldtrip to Chester zoo for #BR24310. Back to teaching biodiversity of the microbial kind for the rest of the week!
English

Just back from a work placement visit to the National Trust at Llanerchaeron. Nice to see our WEP students doing so well! #RDW0160.
English







